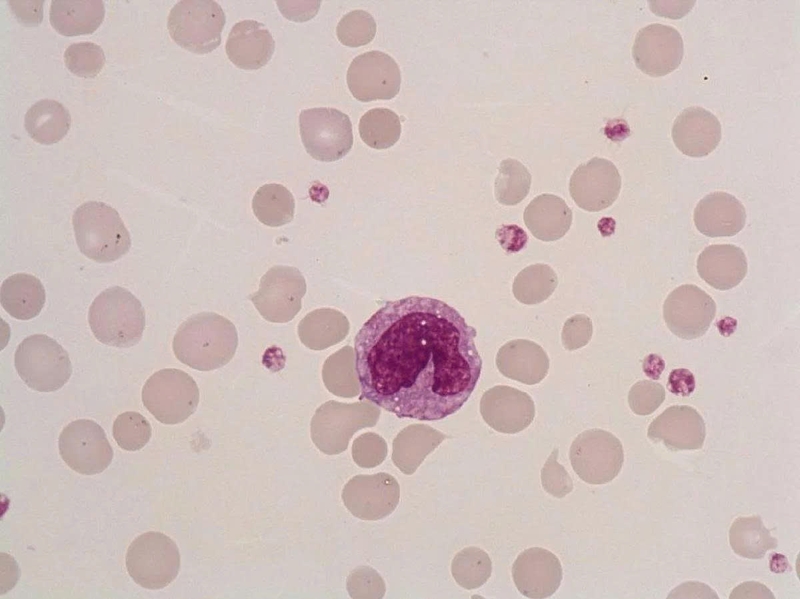
Mono trong xét nghiệm máu là gì? Hướng dẫn hiểu kết quả cho người mới 3

Dược sĩ Đại học có nhiều năm kinh nghiệm trong việc tư vấn Dược phẩm và hỗ trợ giải đáp thắc mắc về Bệnh học. Hiện đang là giảng viên cho Dược sĩ tại Nhà thuốc Long Châu.
Ngọc Diễm
18/12/2025
Mặc định
Lớn hơn
Khi đi khám sức khỏe, bạn có thể bắt gặp chỉ số Mono trong kết quả xét nghiệm máu. Đây là một thành phần quan trọng trong hệ miễn dịch, giúp cơ thể chống lại các bệnh nhiễm trùng. Tuy nhiên, với nhiều người, ý nghĩa của chỉ số này vẫn còn khá mơ hồ. Hãy để chúng tôi giúp bạn giải thích Mono trong xét nghiệm máu là gì, cách đọc kết quả và những thông tin cơ bản giúp bạn hiểu rõ hơn về sức khỏe của mình nhé!
Hiểu được Mono là gì chỉ là bước khởi đầu để nắm rõ tình trạng sức khỏe của bạn. Tuy nhiên, việc chỉ biết tên chỉ số thôi là chưa đủ, để thực sự hiểu ý nghĩa của kết quả xét nghiệm, bạn cần tìm hiểu cách đo, các mức bình thường, những tình trạng sức khỏe có thể khiến chỉ số Mono tăng hoặc giảm, cũng như cách diễn giải kết quả trong bối cảnh sức khỏe tổng thể. Bài viết này sẽ giúp bạn khám phá được những khía cạnh của chủ đề "Mono trong xét nghiệm máu là gì" cũng như một số thông tin cần nắm.
Mono, hay còn gọi là bạch cầu đơn nhân, là một loại tế bào máu trắng quan trọng trong hệ miễn dịch. Chúng đóng vai trò bảo vệ cơ thể khỏi vi khuẩn, virus và các tác nhân gây bệnh, đồng thời giúp loại bỏ các tế bào chết. Mono là một phần không thể thiếu để duy trì sức khỏe tổng thể và khả năng miễn dịch.
Trong các xét nghiệm máu tổng quát, chỉ số Mono được đo để đánh giá số lượng và tỷ lệ bạch cầu đơn nhân trong cơ thể. Việc theo dõi chỉ số này giúp phát hiện các bất thường liên quan đến hệ miễn dịch, tình trạng nhiễm trùng, viêm hoặc một số bệnh lý khác. Nhờ đó, bác sĩ có thể đưa ra những đánh giá chính xác hơn về sức khỏe của người bệnh.

Mono không chỉ là một chỉ số trên phiếu xét nghiệm mà còn đóng vai trò quan trọng trong hệ miễn dịch của cơ thể. Hiểu rõ chức năng của Mono sẽ giúp bạn nắm bắt được cách cơ thể phòng chống nhiễm trùng, loại bỏ tế bào chết và duy trì sức khỏe tổng thể.

Biết được chỉ số bình thường của Mono sẽ giúp bạn nhận biết khi nào cơ thể đang hoạt động khỏe mạnh và khi nào có thể xuất hiện các bất thường cần theo dõi hoặc tư vấn y tế. Chúng ta sẽ tìm hiểu mức bình thường của Mono, cách đọc kết quả và những yếu tố có thể ảnh hưởng đến chỉ số này.
Chỉ số bình thường của Mono được xác định dựa trên số lượng tuyệt đối và tỷ lệ phần trăm trong tổng số bạch cầu:
Các mức này có thể biến đổi tùy theo tuổi, giới tính, tình trạng sức khỏe và phương pháp xét nghiệm của từng phòng lab. Vì vậy, khi đọc kết quả, bạn nên tham khảo giá trị tham chiếu do phòng xét nghiệm cung cấp và cân nhắc các chỉ số khác của bạch cầu để đánh giá chính xác hơn. Ngoài ra, các yếu tố như nhiễm trùng, stress, thuốc điều trị hoặc bệnh lý mãn tính cũng có thể khiến chỉ số Mono thay đổi tạm thời.
Hiểu rõ các nguyên nhân ảnh hưởng sẽ giúp bạn diễn giải kết quả xét nghiệm chính xác hơn và biết khi nào cần tham khảo ý kiến bác sĩ:
Chỉ số Mono trong máu có thể tăng do nhiều nguyên nhân khác nhau. Một số nguyên nhân phổ biến bao gồm nhiễm virus như cúm, viêm gan hoặc Epstein-Barr, các nhiễm trùng mãn tính như lao, viêm phổi, và các bệnh viêm, rối loạn miễn dịch như viêm khớp dạng thấp hoặc bệnh tự miễn. Ngoài ra, một số bệnh lý về máu cũng có thể làm chỉ số Mono cao hơn bình thường.
Ngược lại, chỉ số Mono có thể giảm khi cơ thể bị suy giảm miễn dịch, do bệnh lý hoặc tác dụng phụ của thuốc, hóa trị, xạ trị. Một số trường hợp nhiễm trùng cấp tính nghiêm trọng cũng có thể khiến Mono tạm thời giảm. Ngoài ra, các rối loạn tủy xương hoặc những tình trạng ảnh hưởng đến sản xuất bạch cầu cũng là nguyên nhân khiến chỉ số này thấp hơn bình thường.

Một chế độ dinh dưỡng hợp lý không chỉ giúp hỗ trợ sản xuất bạch cầu đơn nhân mà còn cải thiện khả năng phòng chống nhiễm trùng, tăng cường sức đề kháng và sức khỏe tổng thể:

Hiểu rõ về Mono trong xét nghiệm máu giúp bạn nắm bắt được phần nào tình trạng hệ miễn dịch của cơ thể và ý nghĩa của các chỉ số trong xét nghiệm. Chỉ số Mono có thể tăng hoặc giảm do nhiều nguyên nhân khác nhau nhưng việc duy trì một chế độ sinh hoạt lành mạnh, ăn uống cân bằng và theo dõi sức khỏe định kỳ sẽ giúp giữ chỉ số này ổn định. Khi cần, hãy tham khảo ý kiến bác sĩ để có đánh giá chính xác và phù hợp với tình trạng sức khỏe cá nhân.
Xem thêm:
Dược sĩ Đại họcNguyễn Mỹ Huyền
Dược sĩ Đại học có nhiều năm kinh nghiệm trong việc tư vấn Dược phẩm và hỗ trợ giải đáp thắc mắc về Bệnh học. Hiện đang là giảng viên cho Dược sĩ tại Nhà thuốc Long Châu.